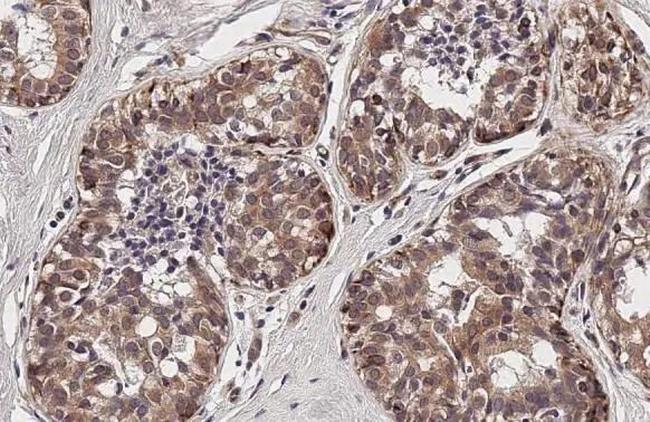
TIGIT Antibody in Immunohistochemistry (Paraffin) (IHC (P))

Search
Invitrogen
TIGIT Recombinant Rabbit Monoclonal Antibody (HL2657)
{{$productOrderCtrl.translations['antibody.pdp.commerceCard.promotion.promotions']}}
{{$productOrderCtrl.translations['antibody.pdp.commerceCard.promotion.viewpromo']}}
{{$productOrderCtrl.translations['antibody.pdp.commerceCard.promotion.promocode']}}: {{promo.promoCode}} {{promo.promoTitle}} {{promo.promoDescription}}. {{$productOrderCtrl.translations['antibody.pdp.commerceCard.promotion.learnmore']}}
图: 1 / 2
TIGIT Antibody (MA5-56897) in IHC (P)


产品信息
MA5-56897
种属反应
宿主/亚型
Expression System
分类
类型
克隆号
抗原
偶联物
形式
浓度
纯化类型
保存液
内含物
保存条件
运输条件
RRID
靶标信息
TIGIT is a 26 kDa protein that belongs to the poliovirus receptor (PVR) family. It is expressed on NK cells, regulatory T cells, follicular T helper cells, memory CD4+ T cells, and CD8+ T cells, but not on B cells or naive CD4+ T cells. However, TIGIT can be upregulated on naive CD4+ T cells upon activation. TIGIT interacts with members of the PVR and PVR-like families, including CD155. This interaction mediates the engagement of NK and T cells with antigen-presenting cells, fibroblasts, and endothelial cells expressing PVR and PVR-like proteins. Binding of TIGIT to PVR leads to increased secretion of IL-10 and decreased secretion of IL-12B, promoting the generation of mature immunoregulatory dendritic cells and suppressing T cell activation. Through these interactions, TIGIT plays a significant role in modulating immune responses and maintaining immune homeostasis.
仅用于科研。不用于诊断过程。未经明确授权不得转售。
篇参考文献 (0)
生物信息学
蛋白别名: T cell immunoreceptor with Ig and ITIM domains; T-cell immunoreceptor with Ig and ITIM domains; V-set and immunoglobulin domain containing 9; V-set and immunoglobulin domain-containing protein 9; V-set and transmembrane domain containing 3; V-set and transmembrane domain-containing protein 3; Washington University cell adhesion molecule
基因别名: TIGIT; VSIG9; VSTM3; WUCAM
UniProt ID: (Human) Q495A1
Entrez Gene ID: (Human) 201633